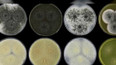
Nová houba se jmenuje po Čechovi

14. června 2024
Obsah dílu
Podezření na terorismus v Česku — Pět dní od eurovoleb: co se změnilo — Petice žádá odstoupení rektorky AVU — Nová houba se jmenuje po Čechovi
Části dílu

Přehled dílů

31. března

30. března
Jak zkrotit zdražování pohonných hmot? — Jak dlouho potrvá válka na Blízkém východě? — Co když vyhraje válku Rusko? — Bossing a šikana v pražské zoo

27. března
Kde se zastaví ceny paliv? — Přelomový rozsudek v digitálním světě — Výstava na Pražském hradě Fragmenty paměti

26. března
O co teď hrají USA, Izrael a Írán? — EP schválil obchodní dohodu s USA — Klamy a manipulace napříč staletími

25. března
100 dnů od jmenování vlády — Útok na Írán a otřesy na globálním trhu — Chystá se bič na neziskové organizace?

24. března
Zdražují hnojiva i pohonné hmoty — Omezit televizní a rozhlasové poplatky? — Největší zátah v historii českého fotbalu — Z psychiatra válečný zločinec

23. března
Zaostřeno na čerpací stanice — Zemřela Božena Jirků — Zabezpečení zbrojních firem v Česku — Cena divadelní kritiky za herecký výkon

20. března
Požár v Pardubicích a podezření na terorismus — Prezident: Šetřit na obraně je krátkozraké — Předvolební kampaň v Maďarsku — Děti s Downovým syndromem

19. března
Orbán blokuje půjčku Ukrajině — Ceny ropy a plynu rostou — Prezident může přijít o jednu z pravomocí — Banksyho tajemství odhaleno

18. března
Babiš: na summit NATO pojedu já a Macinka — Výsledky a důsledky útoku na Írán — Česká debata o TV a rozhlasu pohledem zvenčí



